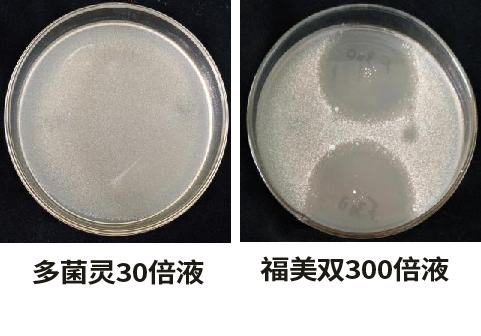
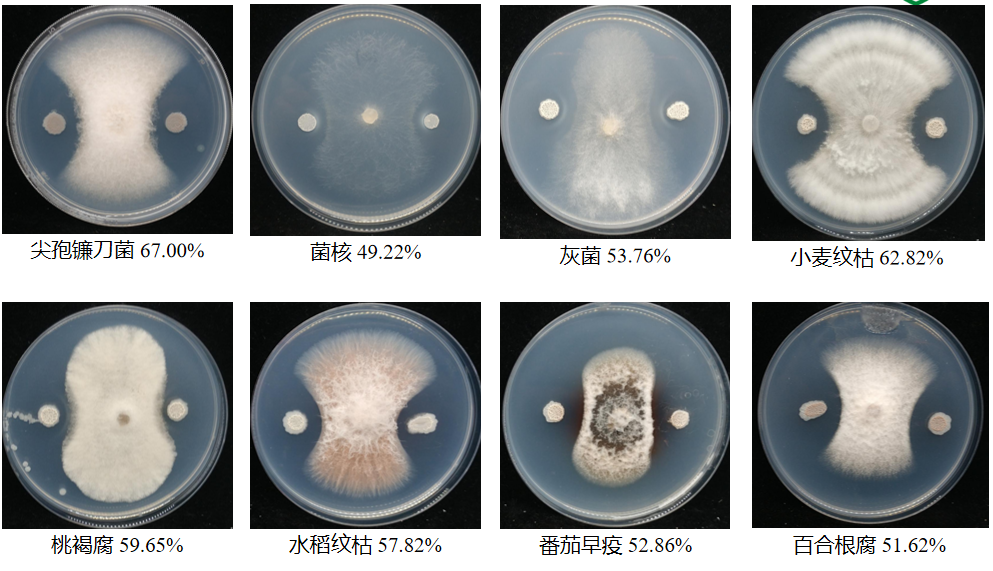
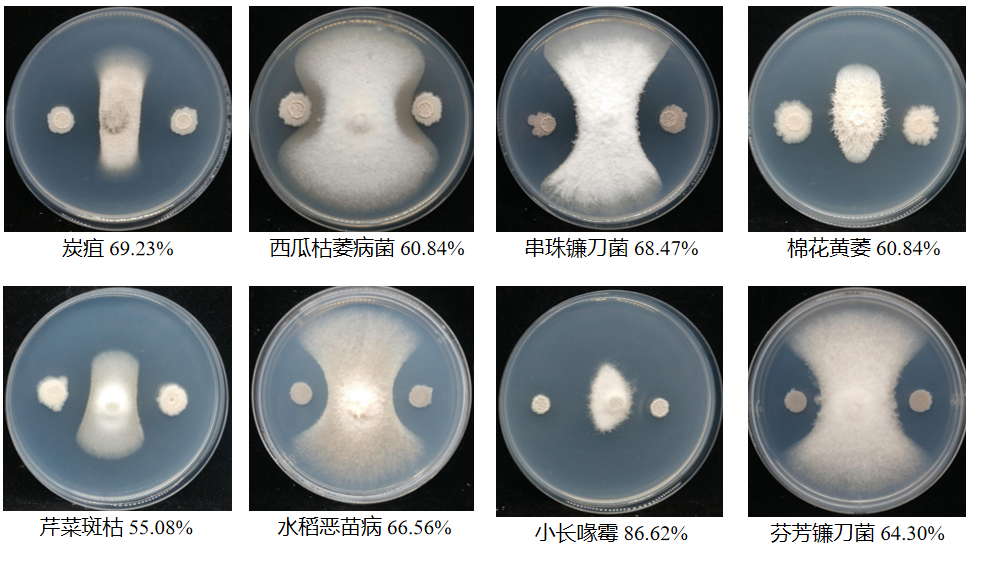

你给你的菌剂加粮食了吗?
近年,随着农业的迅速发展,病害、虫害、农药残留及蔬菜品质问题日趋严重,防治成本越来越高,效果却不甚理想。为更好的服务中国农业,早日实现农业现代化,针对病害防治、作物促生,发展高品质种植,根力多生物科技股份有限公司联合国内外知名院所,深入田间地头、设施大棚、果园等进行数千场次的试验示范和技术方案摸索,进行生防产品的开发和创新。2021年,在作物病害防治及作物促生上,根力多股份菌之力表现突出,赢得了广大渠道商与农户的高度赞扬。

商品名称:根力多®菌の力(抑病型、生根型)
主要技术指标:有效活菌数≥10亿/ml
剂型:水剂
产品规格:5kg×4桶/箱
根力多®菌の力介绍
本品采用根力多股份最新一代生防、促生功能性菌群为核心菌种。生防型功能菌——K01芽孢杆菌具有释放有机磷,产生植物激素,促进根系生长,同时还可分解蛋白纤维素,对许多病菌具有抑制作用;促生型功能菌——N24芽孢杆菌具有繁殖速度快(实验室24分钟)、耐低温、酸化、盐碱等环境胁迫,根区定制率高。
根力多®菌の力的五大特点
1个核心菌种
根力多股份联合中国农业大学、中国农业科学院植物保护所等科研院所平台共同致力于微生物菌株的筛选。

2012年,根力多在新疆分离到K01菌株。2013年1月将菌株保存于中国典型培养物保藏中心,保藏编号:M201320;保藏名称:解淀粉芽孢杆菌;菌株编号:wy-201302。


2016-2019年1月份完成17省、134种作物示范,发现该菌株在作物病害防治方面效果显著。



2020年,通过对K01进行基因组分析,基因组收录号:CPD59344.1。通过比对发现K01与FZB42菌株基因相似,至此,农业部将其命名为贝莱斯芽孢杆菌。
2重筛选
菌种经过耐药、耐高温两重筛选,确保菌的活性。

(耐药筛选)


(耐高温筛选)
3重发酵
更有利于菌种扩繁,保证菌种活性,避免菌种功能退化;
4菌组合
核心菌种+枯草芽孢杆菌+地衣芽孢杆菌+巨大芽孢杆菌;
5S车间全程无菌灌装
保证菌种不被污染。
根力多®菌の力的功效

1、针对性强
产品中含有的K01等有益微生物菌具有占位强、竞争强、产生有益代谢物的作用,对经作、保护地等作物的根腐、炭疽、灰霉、菌核、枯萎、黑胫等土传病菌抑制率达到50-70%;

(植物病原菌真菌抑菌谱)
2、作用谱广
兼具抑病、促生和营养三大功效。有益微生物菌产生的代谢物可刺激作物生长,同时还能分解土壤固化的营养,提高利用率;
3、效果显著
有益微生物菌可抑制有害病菌,可减少用药次数,促生明显,大幅度提高作物品质,实现绿色生态种植。

1、沃土促根
产品中含有的巨大芽孢杆菌可降解盐渍化,地衣芽孢杆菌可抑制土传病害,枯草芽孢杆菌可壮根促苗;
2、解害生根
对因病害、盐害、冻害和肥害造成根系损害的状况,本品含有的N24促生功能性菌株繁殖速度快,产生的代谢物可促进根尖和毛细根再生,增强抗逆性;
3、促长保根


有益微生物菌在繁殖过程中产生的代谢物可以起到扩大根区、延长根系,同时健壮地上植株的作用。

根力多®菌の力的使用方法

根力多®菌の力的神秘伴侣——菌の粮
你给你的菌加粮食了吗?相信很多人会感到新奇。市面上,微生物菌剂各式各样,菌粮还是闻所未闻。此次根力多强势推出菌の力伴侣“菌粮”,为菌提供粮食。什么菌粮的?菌粮里都有什么呢?

有机氮磷钾:12%
有机质≥35%(矿源黄腐酸)
有效活菌数(cfu)≥2亿/克
粗蛋白≥25%(发酵血液)
总糖≥63g/L
还原糖:28g/L(营养)
胞外多糖:5mg/ml(促生)
小分子碳:15%(生物刺激素)
根力多®菌の力在各种作物上的应用案例
众所周知,长年种植的大棚内土壤盐渍化、根腐等病害十分严重。俗话说:实践是检验真理的唯一标准,为了验证菌の力的效果,根力多团队在山东、河北等地设立了试验田进行产品检验。
示范时间:2021年2月
示范地点:山东省济南市商河县、聊城市东阿县及河北省衡水市饶阳县等
使用产品:根力多®菌の力、菌粮




通过对比对照田长势,我们可以看到使用菌之力的作物根系十分强壮,毛细根发达,作物品质也有了明显改变,使用其他产品的作物根系弱,扎根浅,茎部纤细。菌之力的使用效果得到当地种植户的认可,纷纷对根力多竖起大拇指。
示范时间:2021年3月
示范地点:山东省聊城市莘县芸豆大棚
使用产品:根力多®菌の力、菌粮


3月13日,王爱琴的芸豆棚第一次施用菌の力,那时候的芸豆叶片黄化、根系老化,新根生长困难,芸豆夹也十分小。短短20天,王爱琴的芸豆棚就发生了巨大变化。与之前相比,棚内一片生机盎然的绿色,与未冲施根力多菌之力时的样子形成强烈对比。棚主王爱琴对根力多菌の力效果十分满意,她说道:“要不是肥料好,芸豆根本就长不起来。”


